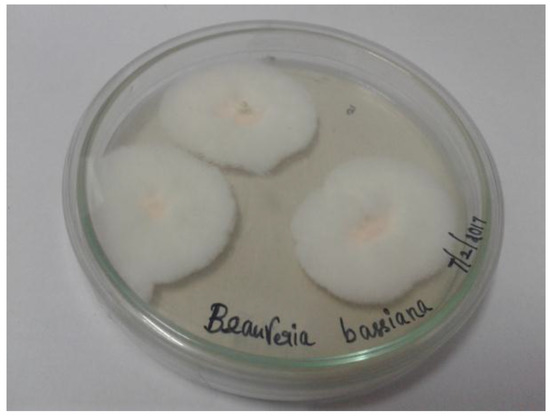

from web site
Tio Breno passa a vara no garoto que era seu f dos filmes gays. O macho mete com forte na bunda do viado e o faz gemer alto com as bombadas.
Quem acompanha o cenrio porn nacional conhece muito bem o Tio Breno, aquele tiozo gostos, com seu jeito de macho e viril. Tambm conheci.
Tio Breno; Tio Breno Metendo No . Xvideos.com F92e507e6752ebd4ff51586d5c629a68; Tio E Sobrinho Tocando Uma Na Cam; Espaol Pollon Se .
Share & Connect with Your Friends.
Gay Tio Breno E Sobrinho Gustavo porn videos free online and download on CumFinder - Sobrinho gay chupando o pau do tio - www.arquivogls.com
3bb9090bfc
raster nng v1.0 19
LS-Land.Issue-LS.Magazine.LS.Models.03.Little.Pirates.15
download album aerosmith greatest hits 20
iso naruto ultimate ninja storm 3 for pcsx3 22
'z Movie (1998).16
rabhasa video songs hd 1080p download 29
download for free billionaire revenge marie kelly.80
TVPaint Animation 10 Pro 10.0.16 (64 13
Battle Vs Chess 18
uncha lamba kad full song hd 1080p blu 52